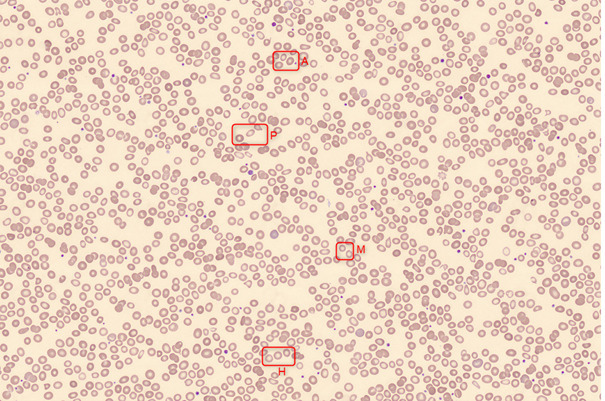

L’anémie par carence en fer est très fréquente, touchant entre 20 et 30 % de la population mondiale. Mais la carence martiale est encore plus fréquente que l’anémie. Elle est souvent sous-diagnostiquée, notamment dans les maladies chroniques qui s’accompagnent d’une inflammation chronique à bas bruit. On estime qu’entre 25 et 50 % des insuffisants rénaux chroniques, des insuffisants cardiaques, des patients atteints de cancers et des patients avec MICI ont une carence martiale.
Cette dernière se définit comme la condition où le fer n’est pas disponible pour les besoins de l’organisme. Elle peut être présente avec ou sans anémie. Les symptômes cliniques d’une carence sont polymorphes et ne sont pas toujours d’une grande aide pour le diagnostic. Le dosage de la ferritine permet de poser facilement le diagnostic de carence absolue, mais diagnostiquer une carence dans un contexte inflammatoire n’est pas toujours aisé. D’autres biomarqueurs aident à différencier le type de carence.
Le métabolisme du fer
En situation « normale », l’alimentation couvre les besoins en fer, qui sont d’environ 4 mg par jour. Le fer est transporté par la transferrine avant d’être utilisé pour son rôle fonctionnel (Hb, myoglobine, enzyme). Le surplus est stocké sous forme de ferritine (foie, rate, moelle osseuse, macrophage). Les pertes physiologiques sont d’environ 2 mg/j. Le fer est recyclé à partir des réserves et un équilibre se fait entre recyclage et utilisation du stock si nécessaire.
La ferroportine régule l’entrée du fer dans les entérocytes et l’export des zones de stockage vers le sang. Ce système est lui-même régulé par une hormone hépatique, l’hepcidine, qui bloque la ferroportine empêchant ainsi le transfert du fer d’un compartiment à un autre. Sa production est stimulée en cas d’inflammation. Dans ces cas, le fer est séquestré par les macrophages et sa mobilisation est insuffisante quel que soit l’état des réserves.
On différencie ainsi la carence martiale absolue où les réserves en fer sont diminuées et la carence martiale fonctionnelle où les stocks sont normaux mais le fer n’est pas utilisable par l’organisme.
Quelles sont les populations à risque ?
Peuvent provoquer une carence absolue :
- des pertes excessives chroniques ;
- une insuffisance d’apport ;
- un besoin accru (grossesse, croissance, sport d’endurance) ;
- une malabsorption du fer.
Une carence fonctionnelle est liée à des maladies inflammatoires chroniques :
- insuffisance rénale chronique ;
- insuffisance cardiaque chronique ;
- maladies auto-immunes ;
- maladies inflammatoires chroniques intestinales ;
- obésité ;
- cancers ;
- infections chroniques.
Une carence martiale peut être à la fois absolue et fonctionnelle lorsqu’un patient a à la fois des saignements et une inflammation chronique comme dans les cancers coliques ou les MICI.
Comment dépister ces carences ?
Des biomarqueurs permettent d’évaluer les stocks en fer des différents compartiments.
Biomarqueurs des réserves
Laferritine est le meilleur reflet des réserves. C’est l’examen de référence pour diagnostiquer une carence absolue. Une valeur basse traduit une carence martiale avec une très bonne spécificité. Mais la ferritine est augmentée dans les conditions inflammatoires rendant ce biomarqueur peu utile isolément en cas d’inflammation. Dans ce cas, d’autres paramètres sont nécessaires pour faire le diagnostic.
Le dosage du fer isolé n’a aucun intérêt car il est sujet à des variations nycthémérales importantes. Son dosage doit être associé à celui de la transferrine pour calculer le coefficient de saturation de la transferrine.
Biomarqueurs du compartiment circulant
Le dosage de la transferrine (ou sidérophiline), couplée au dosage du fer sérique, mesure le coefficient de saturation en transferrine (CST) selon la formule : CST ( %) = fer (µmol/L) / capacité totale de fixation de la transferrine (CTF) (µmol/L) avec CTF = transferrine dosée (g/L) x 25.
Sa valeur normale varie entre 20 et 40 %. C’est un bon indicateur du transport et de la livraison du fer, reflétant en premier lieu le fer disponible pour l’érythropoïèse.
Un taux bas signe un défaut d’approvisionnement en fer de la moelle osseuse. Il est donc diminué en cas de carence martiale absolue ou d’inflammation.
Témoins du compartiment cellulaire
Les paramètres des globules rouges sont les plus longs à se modifier et sont le reflet tardif du déficit en fer. La carence prolongée entraîne une anémie qui sera d’abord normocytaire puis microcytaire et arégénerative. La CCMH et la TCMH diminuent également (respectivement : concentration et teneur corpusculaires moyennes en hémoglobine). La microcytose est progressive : de jeunes et petites hématies apparaissent dans la population « normale » d’hématies entraînant des tailles différentes de ces dernières qu’on nomme anisocytose et qui se traduit par un paramètre RDW (red cell distribution width) augmenté sur l’hémogramme. Le VGM (volume globulaire moyen), CCMH et TCMH figurent sur les comptes-rendus de laboratoire, contrairement au RDW.
Le pourcentage de globules rouges circulants hypochromes (par rapport aux globules rouges totaux) est également un marqueur de carence martiale.
Le contenu en hémoglobine des réticulocytes est un indicateur très précoce du statut martial. Il indique le fer disponible pour l’érythropoïèse durant les trois à quatre jours qui précèdent le prélèvement, témoin précoce d’une érythropoïèse inefficace. En cas de valeur basse, le diagnostic de carence martiale est posé.
Cependant, ces deux paramètres ne figurent pas systématiquement sur les comptes-rendus et requièrent l’analyse des réticulocytes.
L’examen du frottis sanguin montre des anomalies de la lignée érythrocytaire (anisocytose, microcytose, hypochromie, poïkilocytose). Ces anomalies sont tardives par rapport au début de la carence (figure).
Le taux des récepteurs solubles à la transferrine (RsTrf) reflète les besoins en fer de l’organisme pour l’activité érythropoïétique. Dans la carence martiale absolue, les RsTrf sont augmentés, alors que dans la carence fonctionnelle, le taux des RsTrf est normal ; ils ne sont pas influencés en cas de contexte inflammatoire. Ils sont un témoin sensible et très précoce des carences absolues.
S’il y a simultanément un état ferriprive absolu et un état inflammatoire, le dosage de la ferritine sera souvent normal et seule l’élévation du taux de RsTrf permettra de faire le diagnostic de carence martiale associée à l’état inflammatoire. Cependant, son dosage n’est pas standardisé et n’est pas comparable d’un laboratoire à un autre. Il est possible de calculer le ratio récepteur soluble de la transferrine/log ferritine (RsTrf/log ferritine) qui sera diminué en cas de déficit fonctionnel, et > 2 en cas de carence martiale absolue ou en cas de carence mixte (tableau).
Enfin, le dosage de l’hepcidine (hormone de régulation) n’est réalisé qu’en laboratoire spécialisé.
⇒ Ainsi, de nombreux marqueurs sont le témoin d’une carence martiale mais les biomarqueurs les plus performants – à utiliser en première intention – sont la ferritine et le CST. Le dosage des RsTrf peut être utile si la ferritine et le CST sont insuffisants pour le diagnostic.
Quels seuils pour la ferritine et le CST ?
Dans la population générale, l’Organisation mondiale de la santé définit un seuil de carence martiale quand la ferritine est 15 µg/L chez l’adulte et 12 µg/L chez l’enfant. Cependant le seuil de 30 µg/L a été identifié comme plus sensible (92 %) et plus spécifique (98 %) de la carence martiale.
Dans un contexte infectieux ou inflammatoire chronique, les recommandations des différentes sociétés savantes varient mais les experts s’accordent pour un consensus avec un seuil de ferritine de 100 µg/L ou un CST 20 %, ou une ferritine comprise entre 100 - 300 µg/L nécessitant alors une confirmation par CST ( 20 %).
Quel traitement ?
Ces notions de carence absolue ou fonctionnelle sont importantes pour adapter au mieux le traitement. En effet, dans le cas d’une maladie chronique avec carence fonctionnelle, l’administration per os de fer sera inutile car l’excès de production d’hepcidine bloquera l’activité de la ferroportine, rendant impossible la fonction d’export de ce transporteur du fer cellulaire vers le secteur circulant.
L’administration IV permettra de « shunter » la voie entérocytaire.
Qu’en retenir ?
Carence martiale ABSOLUE :
Ferritine 30 µg/L
Carence martiale FONCTIONNELLE :
Ferritine 100 µg/L ou CST 20 %
Ferritine comprise entre 100 - 300 µg/L + CST 20 %
Carence martiale MIXTE :
Ferritine : 30 - 100 µg/L
CST : 20 %
Jung HL. Absolute versus functional iron deficiency. Clin Exp Pediatr 13 novembre 2024.
Cappellini MD, Comin-Colet J, de Francisco A, et al. Iron deficiency across chronic inflammatory conditions: International expert opinion on definition, diagnosis, and management. Am J Hematol 2017;92(10):1068-78.
Rohr M, Brandenburg V, Brunner-La Rocca HP. How to diagnose iron deficiency in chronic disease: A review of current methods and potential marker for the outcome. Eur J Med Res 2023;28(1):15.
Dignass A, Farrag K, Stein J. Limitations of Serum Ferritin in Diagnosing Iron Deficiency in Inflammatory Conditions. Int J Chronic Dis 2018;2018:9394060.
Cappellini MD, Musallam KM, Taher AT. Iron deficiency anaemia revisited. J Intern Med 2020;287(2):153-70.
Cacoub P, Choukroun G, Cohen-Solal A, et al. Towards a Common Definition for the Diagnosis of Iron Deficiency in Chronic Inflammatory Diseases. Nutrients 2022;14(5):1039.
Cohen-Solal A, Philip JL, Picard F, et al. Iron deficiency in heart failure patients: the French CARENFER prospective study. ESC Heart Fail 2022;9(2):874-84.
Guibergia C, Brazier F, Choukroun G. Management of iron deficiency in chronic kidney disease: Review and proposed algorithm. Nephrol Ther 2022;18(7):658-65.
Cacoub P, Choukroun G, Cohen-Solal A, et al. Iron deficiency screening is a key issue in chronic inflammatory diseases: A call to action. J Intern Med 2022;292(4):542-56.